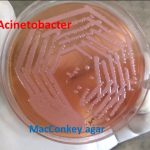
Acinetobacter on MacConkey agar
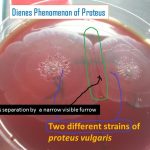
Dienes phenomenon of Proteus

Collection Group: Clinical Bacteriology
Acinetobacter: Genus definition, Habitat, Morphology, Pathogenecity, Lab Diagnosis and Treatment
Acinetobacter Acinetobacter calcoaceticus -baumanii complex on MacConkey agar is resembling...
Acinetobacter Acinetobacter calcoaceticus -baumanii complex on MacConkey agar is resembling...
Streptobacillus Gram Stain: Introduction, Principle, Procedure and Result Interpretation
 Introduction of Streptobacillus Streptobacillus species are on Gram stain showing Gram-negative...
Introduction of Streptobacillus Streptobacillus species are on Gram stain showing Gram-negative...
Dienes Phenomenon of Proteus: Introduction,Test Procedure, Result Interpretation and Uses
Introduction of Dienes Phenomenon Dienes phenomenon from the name of...
Introduction of Dienes Phenomenon Dienes phenomenon from the name of...
